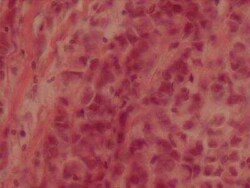
Novus Biologicals Human Breast Tissue Lysate (Adult Tumor) 0.1 mg | Buy Online | Novus Biologicals&trade; | Fisher Scientific

missing translation for 'onlineSavingsMsg'
Learn More
Learn More
Specifications
Specifications
| Preparation Method | These lysates are proteomic discovery tools.Researchers should validate and optimize for individual use. Potential applications MAY include WB, immunoprecipitation, protein-protein interactions, ligand binding, ELISA. Note: For use in 1D and 2D gel electrophoresis, the addition of a denaturing gel loading buffer with reducing agents may be required. |
| Quantity | 0.1 mg |
| Content And Storage | Store at -20°C short term. Aliquot and store at -70°C long term. Avoid freeze-thaw cycles. |
| Target | Breast |
Product Title
By clicking Submit, you acknowledge that you may be contacted by Fisher Scientific in regards to the feedback you have provided in this form. We will not share your information for any other purposes. All contact information provided shall also be maintained in accordance with our Privacy Policy.
Spot an opportunity for improvement?